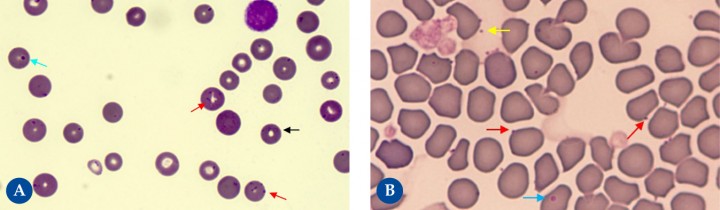
<p><strong>Micoplasmas hemotrópicos</strong>. Hay diferentes especies de micoplasmas hemáticos que afectan a gatos: <em>Mycoplasma haemofelis</em> (Fig. 4<strong>A</strong>), <em>Candidatus M. haemominutum</em> y <em>Candidatus M. turicensis</em>; así como a perros: <em>M. haemocanis</em> (Fig. 4<strong>B</strong>) y <em>Candidatus M. haematoparvum</em>. El cuadro clínico (desde detección incidental a anemia hemolítica) depende de la especie y de posibles patologías concomitantes. Son bacterias muy pequeñas, de 0,1 a 1 μm (<em>M. haemofelis</em>, la más patogénica en gatos, es la de mayor tamaño), que se sitúan sobre la superficie de los eritrocitos en forma de cocos, bastoncillos y raramente en anillo (flecha negra). En ocasiones también pueden observarse libres sobre el fondo de la preparación (flecha amarilla). No deben confundirse con cuerpos de Howell-Jolly (flecha azul), habitualmente de mayor tamaño, ni con restos de tinción u otros detritus. Se identifican más fácilmente (flechas rojas) cuando se presentan en cadenas o la disposición epicelular es más evidente. Se detectan mejor en muestras de sangre capilar y en frotis frescos. Ante poca cantidad de microorganismos es recomendable realizar pruebas de PCR que, además, permiten determinar la especie.</p>

Visualización de agentes patógenos en el frotis sanguíneo
El estudio microscópico del frotis sanguíneo se utiliza comúnmente para la identificación de agentes infecciosos. Estos microorganismos pueden encontrarse libres en el plasma (sobre el fondo de la preparación) o afectando diferentes células sanguíneas. Dependiendo de su tamaño, algunos de ellos se pueden detectar mediante el objetivo de 10 aumentos (10x), mientras que otros van a requerir el objetivo de inmersión (100x). La sensibilidad de la técnica depende de la cantidad de microorganismos, posibles citopenias del paciente, la experiencia del observador y el tiempo invertido en el estudio del frotis. La especificidad depende principalmente de los conocimientos del observador y, en parte, también de la conservación de la muestra. Las técnicas de reacción en cadena de la polimerasa (PCR), que están disponibles para algunos agentes infecciosos, pueden utilizarse como un complemento de la observación microscópica, pero no deberían sustituir el examen completo del frotis sanguíneo.

Artículos recomendados
Estas recomendaciones se ofrecen de forma automática.
-
Galería de imágenes – Cirugía reconstructiva
Cristina Rizkallal Santana.Clin Vet Peq Anim Vol. 46 - Nº 1 · MAR 2026 · Galería de imágenes
-
Galería de imágenes – Anestesia y analgesia
A. Meneses-García, T. Mangas-Ballester, J. Viscasillas, et al.Clin Vet Peq Anim Vol. 45 - Nº 4 · DIC 2025 · Galería de imágenes
-
Galería de imágenes – Cirugía de tejidos blandos
A. García-Ferrer, N. Vizcaíno-RevésClin Vet Peq Anim Vol. 45 - Nº 3 · SEP 2025 · Galería de imágenes


